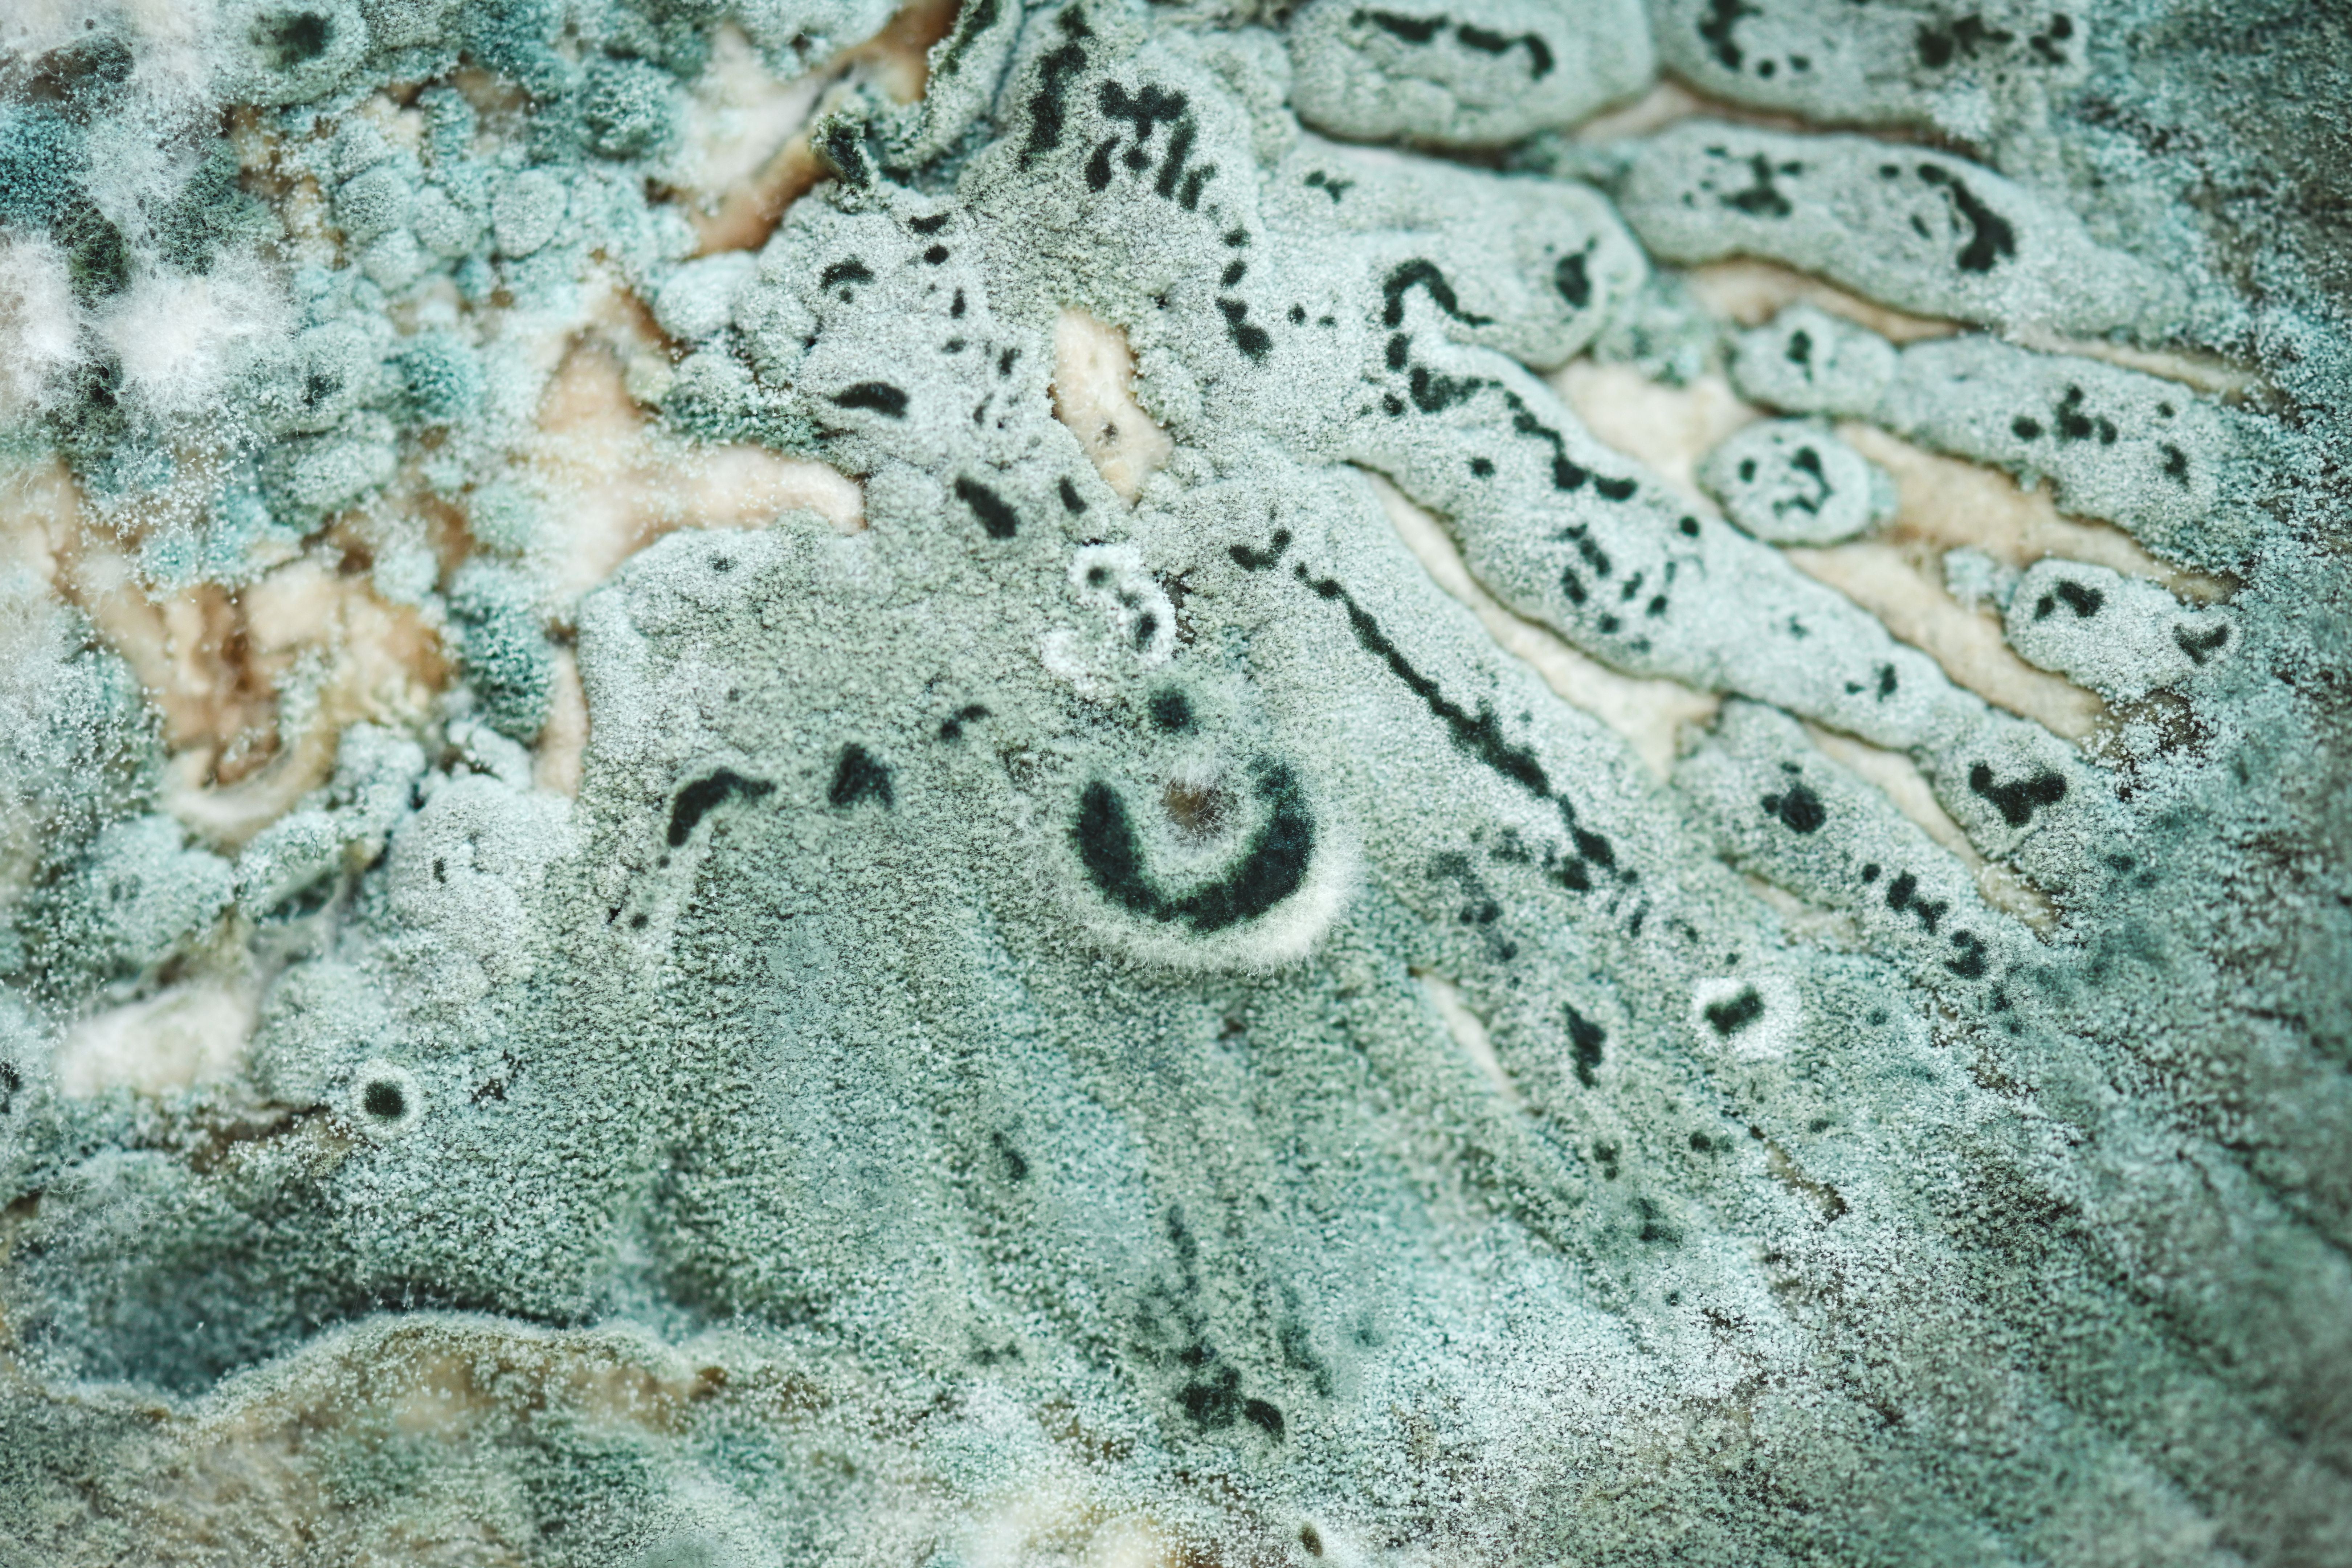
mushroom spores

DIY Mushroom Cultivation: Tips from Boise's Gourmet Experts
Introduction to DIY Mushroom Cultivation
Mushroom cultivation at home is not only a rewarding hobby but also a great way to ensure a fresh and sustainable supply of this nutrient-rich food. In Boise, a growing community of gourmet experts is sharing their wisdom and techniques for successful DIY mushroom farming. Whether you're a beginner or have some experience under your belt, these tips will help you get started on your mushroom cultivation journey.

Selecting the Right Mushroom Species
Choosing the right species is crucial for successful mushroom cultivation. Oyster mushrooms, shiitake, and lion's mane are popular choices among Boise's gourmet experts due to their adaptability and unique flavors. Consider your climate, available space, and personal taste preferences when selecting a species to grow.
Oyster Mushrooms
Oyster mushrooms are known for their rapid growth and ease of cultivation. They thrive in a variety of substrates, making them an excellent choice for beginners. These mushrooms have a mild flavor, complementing various dishes.
Shiitake Mushrooms
Shiitake mushrooms require more specific conditions but are highly valued for their rich, umami flavor. They typically grow on hardwood logs or sawdust blocks, offering a rewarding challenge for more experienced growers.

Creating the Ideal Growing Environment
The environment in which mushrooms grow plays a significant role in their development. Boise's climate offers unique challenges and opportunities for mushroom cultivation. Key factors to consider include temperature, humidity, and light.
Temperature and Humidity
Mushrooms generally prefer temperatures between 55°F and 75°F. Maintaining consistent humidity levels around 85-95% is crucial for their growth. Use a humidifier or mist your growing area regularly to achieve these conditions.
Lighting Conditions
While most mushrooms don't require direct sunlight, they do benefit from some indirect light. A simple fluorescent light can suffice if you're growing indoors. Ensure your growing space maintains a natural day-night cycle for optimal results.

Substrate Preparation and Inoculation
The substrate is the material on which mushrooms grow and derive nutrients. Common substrates include straw, sawdust, and coffee grounds. Proper preparation and inoculation are crucial steps in successful cultivation.
Preparing the Substrate
Substrate preparation involves pasteurizing or sterilizing the material to eliminate competing organisms. This can be done using heat or chemical treatments. Once prepared, the substrate should be cooled before inoculation.
Inoculating the Substrate
Inoculation involves introducing mushroom spores or mycelium into the substrate. This step requires cleanliness to prevent contamination. Spread the spores evenly across the substrate and ensure they have adequate contact for colonization.
Caring for Your Growing Mushrooms
After inoculation, your focus should shift to maintaining optimal conditions for growth. Regular monitoring and adjustments will ensure healthy development and yield.
Monitoring Growth
Check your mushrooms daily for signs of growth or issues such as mold or pests. Adjust environmental factors as needed to promote healthy development. Patience is key, as some species can take several weeks to mature.
Harvesting Your Mushrooms
Mushrooms are ready to harvest when their caps have fully opened but before they start to release spores. Use a sharp knife to cut them at the base, ensuring you leave some stem for future growth.
By following these expert tips from Boise's gourmet community, you can enjoy the satisfaction of cultivating your own mushrooms at home. With practice and patience, you'll soon be harvesting delicious, homegrown fungi that enhance your culinary creations.
